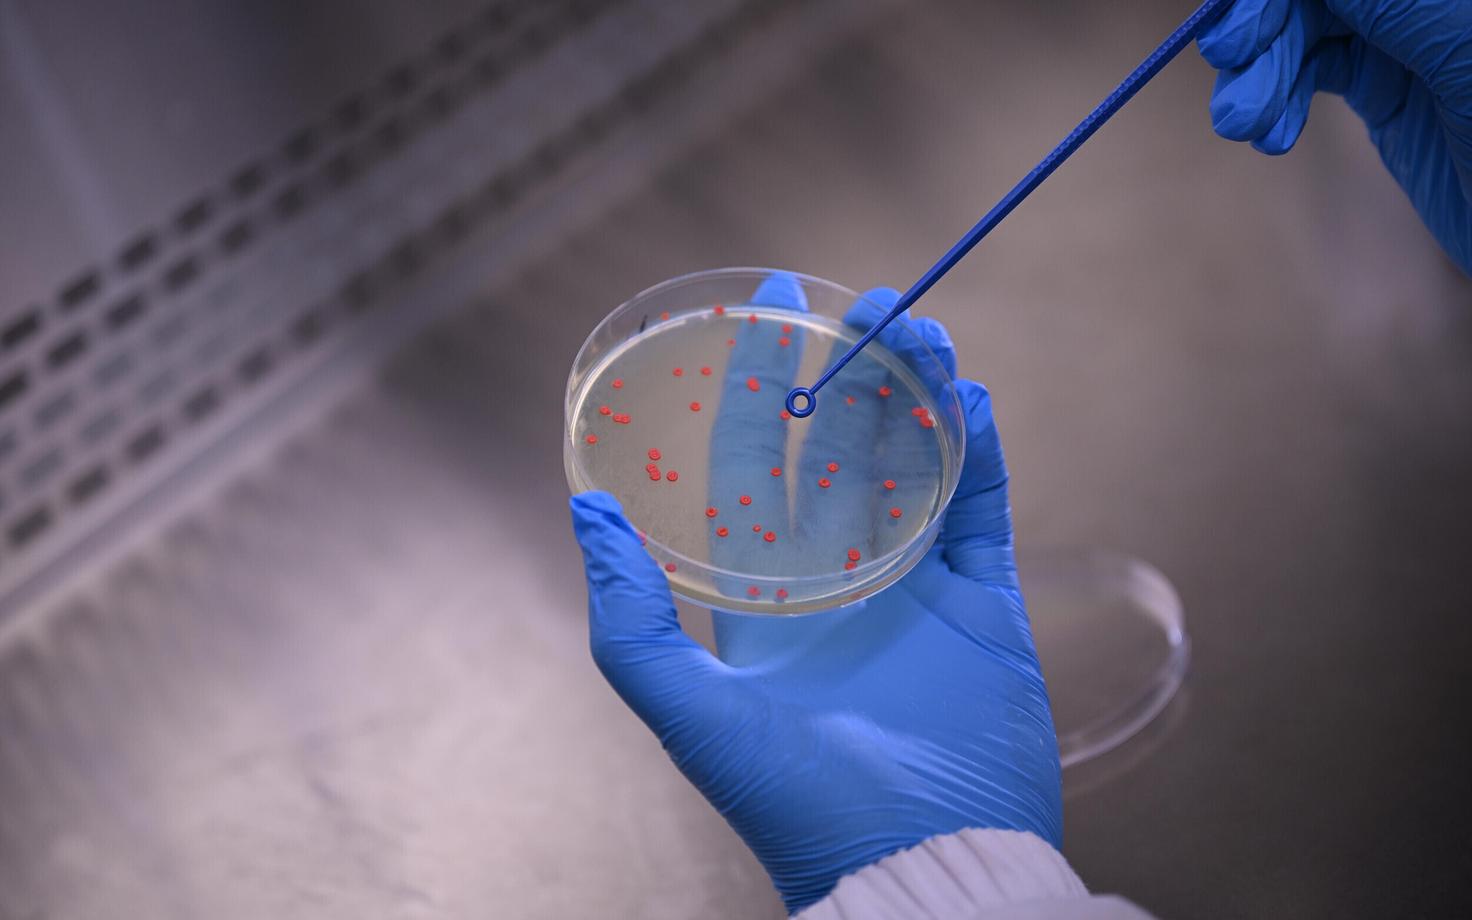
Pärm Rhodontula toruloides

Pärm võib aidata sünteetilised materjalid minevikku jätta
Punast värvi pärm, mida seni on tuntud eeskätt õlide ja pigmentide tootjana, võib tulevikus aidata asendada naftapõhiseid materjale.
Biotehnoloogias on punast värvi pärm Rhodotorula toruloides tuntud oma võime poolest toota väärtuslikke õlisid ja pigmente. Tallinna Tehnikaülikooli teadlased avastasid, et see pärm suudab toota ka suhkrupõhiseid polümeere, mida saaks tulevikus kasutada biopõhise ja jätkusuutlikuma alternatiivina sünteetilistele materjalidele.
Rakuvabrikuid kasutatakse laialdaselt meditsiinis ja toidutööstuses vajalike biokemikaalide tootmiseks. Biotehnoloogia võimaldab aga toota ka jätkusuutlikke materjale, aidates vähendada fossiilkütuste kasutamist. Taimsetel suhkrutel kasvav pärm on rakuvabrikuna üks tuntumaid ja olulisemaid, kuna suudab toota mitmeid väärtuslikke ühendeid.
Õlisid ja pigmente ehk karotenoide toodab pärm Rhodotorula toruloides rakkude sees, kus need ühendid tekivad loomulikult ainevahetusprotsesside käigus. Hiljuti tuvastasid Tallinna Tehnikaülikooli teadlased aga viisi, kuidas pärm suudab toota kasulikke biopolümeere ka väljaspool rakku.
Pärmi biotehnoloogilise potentsiaali uurimisel vaatlesid teadlased pärmirakkude käitumist stressitingimustes. Pärmirakkudes võivad stressi põhjustada keskkonnatingimuste muutused, näiteks happesuse ja soolsuse kõikumine, temperatuuri muutused ning toitainete nappus.
Stressitingimustes kohaneb pärmi ainevahetus ning hakatakse tootma varuaineid või kaitsvaid ühendeid, mida tavatingimustes ei teki. Kunstlike stressitingimuste loomine aitab teadlastel pärmi ainevahetuse potentsiaali paremini mõista.
Üks uuringu juhtautor Rahul Kumar rääkis, kuidas nad panid tähele, et soolastressi mõjul hakkasid R. toruloides'e rakud, mis tavaliselt ujuvad lahuses eraldi, teatud tingimustes moodustama kleepuvaid klompe. See viitas pärmi pinnastruktuuri muutumisele soolase keskkonna mõjul.
"Proovisime katse käigus lisada ka lihtsaid soolasid, nagu naatrium- või kaaliumkloriid, ja meie üllatuseks andis see vastupidise tulemuse, hoopis takistades klompide teket. See andis meile põhjust arvata, et pärmi pinnal toimub mingi keerukam protsess," sõnas Kumar.
Selgus, et pärm reageeris soolasele keskkonnale aktiivselt, hakates tootma ja eritama pinna omadusi muutvaid aineid. Need ained osutusid keerukateks suhkrupõhisteks biopolümeerideks ehk eksopolüsahhariidideks (EPS).
EPS-ühendid on suure tööstusliku potentsiaaliga ained, millel on geelivad ja kleepuvad omadused ning võime moodustada kaitsekihti. Kontrollitud katsetingimustes tootis pärm EPS-i märkimisväärses koguses – kuni kuus grammi liitri kohta. Uurimisrühm töötas välja meetodid pärmi toodetud biopolümeeride tuvastamiseks ja kirjeldamiseks ning selgitas bioinformaatika abil selle protsessi molekulaarse mehhanismi ja seda juhtivad geenid.
Uurimisrühma liige, doktorant-nooremteadur Henrique Hamacek selgitas, kuidas leiti, et happeline keskkond soodustab EPS-i eritumist. "Avastus keskkonna happesuse ja EPS-i tootmise seoste kohta oli meie jaoks väga põnev, kuna see näitab, et pärmi keskkonnatingimusi muutes saab mõjutada nende polümeeride tootmist," ütles ta.
Rahul Kumari sõnul näitab uurimus, et pärmil R. toruloides on seni arvatust suurem biotehnoloogiline potentsiaal, mis ei piirdu üksnes õlide ja karotenoidide tootmisega. "See avab ukse uute jätkusuutlike mikroobipõhiste materjalide arendamisele. Seni on bioprotsesside kitsaskohaks olnud raku sees toodetud ainete eraldamine. Meie töö näitab, et biotehnoloogia võimaldab kasutada pärmi ka teiste biomolekulide tootmiseks väljaspool rakku, mis omakorda suurendab pärmi väärtust rakuvabrikuna," märkis ta.
Uuringu tulemused avaldati ajakirjas Applied and Environmental Microbiology.
Toimetaja: Sandra Saar




















